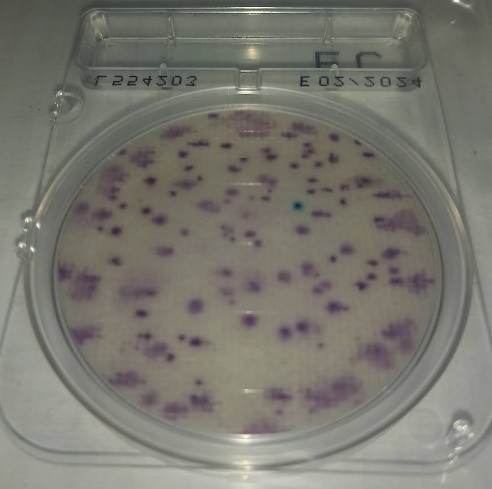

การเปลี่ยนแปลงสภาพภูมิอากาศได้ส่งผลกระทบต่อสภาพแวดล้อมโดยรวมของโลกอย่างต่อเนื่อง และมีแนวโน้มที่จะทวีความรุนแรงมากขึ้นในอนาคต ดังนั้นเพื่อรับมือกับปัญหาการเปลี่ยนแปลงสภาพภูมิอากาศ การลดการปล่อยก๊าซเรือนกระจกและการปรับตัวเพื่อลดผลกระทบจากการเปลี่ยนแปลงสภาพภูมิอากาศ เป็นสิ่งจำเป็นยิ่งที่ต้องเร่งดำเนินการ ทั้งนี้การปล่อยก๊าซเรือนกระจกสุทธิเป็นศูนย์จะเกิดขึ้นได้นั้น ต้องอาศัยทั้งการลดปริมาณการปล่อยและเพิ่มศักยภาพในการดูดกลับหรือกักเก็บคาร์บอนไดออกไซด์
กระทรวงการอุดมศึกษา วิทยาศาสตร์ วิจัยและนวัตกรรม (อว.) โดย สถาบันวิจัยวิทยาศาสตร์และเทคโนโลยีแห่งประเทศไทย (วว.) ร่วมกับพันธมิตรจังหวัดสงขลา 6 หน่วยงาน ได้แก่ จังหวัดสงขลา อำเภอระโนด องค์กรบริหารส่วนตำบลบ้านขาว มหาวิทยาลัยราชภัฏสุราษฎร์ธานี มหาวิทยาลัยสงขลานครินทร์ และชุมชนบ้านขาวหมู่ 2 ภายใต้การสนับสนุนทุนวิจัยโดย หน่วยบริหารและจัดการทุนด้านการพัฒนาระดับพื้นที่ (บพท.) ร่วมดำเนินโครงการ “การเสริมสร้างศักยภาพให้ชุมชนบริหารจัดการลดการปลดปล่อยก๊าซเรือนกระจกด้วยการผลิตน้ำประปาจากน้ำฝน” มีระยะเวลาดำเนินงาน 1 ปี โดยมีเป้าหมายให้ชุมชนมีน้ำสะอาดที่มีคุณภาพใช้อย่างเพียงพอ เพื่อลดความเหลื่อมล้ำ ยกระดับคุณภาพชีวิตของชุมชนด้วยเทคโนโลยี รองรับสังคมคาร์บอนต่ำ พร้อมคัดเลือกครัวเรือนเป็นชุมชนนำร่องในพื้นที่ติดตั้งชุดผลิตน้ำประปาจากน้ำฝนด้วยเทคโนโลยีสีเขียวที่ลดการปลดปล่อยก๊าซเรือนกระจก
ศ .(วิจัย) ดร.ชุติมา เอี่ยมโชติชวลิต ผู้ว่าการ วว. กล่าวว่า การดำเนินโครงการ“การเสริมสร้างศักยภาพให้ชุมชนบริหารจัดการลดการปลดปล่อยก๊าซเรือนกระจกด้วยการผลิตน้ำประปาจากน้ำฝน” จะนำน้ำฝนมาผลิตเป็นน้ำประปาด้วยเทคโนโลยีสีเขียวที่ลดการปลดปล่อยก๊าซเรือนกระจก โดยเป็นระบบที่ไม่ใช้สารเคมีในการตกตะกอนและลดปริมาณน้ำดิบที่เข้าสู่กระบวนการผลิตประปา เพื่อให้องค์กรปกครองส่วนท้องถิ่นสามารถลดต้นทุนการใช้ไฟฟ้าและสารเคมี ที่เป็นปัจจัยหลักในการปลดปล่อยก๊าซเรือนกระจกของระบบผลิตน้ำประปาในปัจจุบัน นอกจากนี้ยังเป็นแนวทางให้กับองค์การปกครองส่วนท้องถิ่นในการลงทุนร่วมกับโรงผลิตอุปกรณ์ถังเก็บน้ำและอุปกรณ์กรองน้ำ เพื่อขยายผลไปยังชุมชนอื่นๆ ทั่วประเทศไทยในการผลิตน้ำประปาจากน้ำฝน (น้ำฝนพร้อมดื่ม) โดยองค์การปกครองส่วนท้องถิ่นเป็นผู้ลงทุนระบบและเก็บค่าใช้น้ำจากชุมชนในแต่ละครัวเรือน ซึ่งจะสามารถลดภาระการจัดหาแหล่งกักเก็บน้ำ ลดการใช้ไฟฟ้าและสารเคมีในการผลิตน้ำประปาให้กับเมืองและชุมชนต่อไป นอกจากนี้ยังสามารถช่วยแก้ปัญหาขาดแคลนน้ำในหน้าแล้งได้อีกด้วย

“....งานวิจัยนี้มีเป้าหมายให้ชุมชนมีน้ำที่สะอาดที่มีคุณภาพใช้อย่างเพียงพอ ซึ่งสามารถนำน้ำมาใช้ได้ทั้งอุปโภค และบริโภค โดยไม่ขาดแคลนน้ำ เพื่อลดความเหลื่อมล้ำทางสังคมและยกระดับคุณภาพชีวิตชุมชน สำหรับข้อมูลการปลดปล่อยก๊าซเรือนกระจกที่ได้จะเป็นข้อมูลในเชิงพื้นที่หรือชุมชน ซึ่งหากสามารถขยายผลไปยังทุกครัวเรือน จะสามารถนำไปคำนวณสู่ฐานข้อมูลบัญชีการปลดปล่อยก๊าซเรือนกระจกในระดับตำบล อำเภอและจังหวัดได้ ส่งเสริมให้ชุมชนมีความรับผิดชอบต่อสังคมและสิ่งแวดล้อมร่วมกัน ในการนำน้ำฝนมาผลิตเป็นน้ำประปาพร้อมใช้ และดื่ม และลดการใช้ขวดพลาสติกบรรจุน้ำดื่ม เพื่อลดการปลดปล่อยก๊าซเรือนกระจก เพื่อให้เกิดแนวทางสำหรับการจัดการน้ำในเมืองคาร์บอนต่ำ ด้วยเทคโนโลยีสีเขียวในการผลิตน้ำประปาจากน้ำฝน ตามแผนที่นำทาง WaCCliM เพื่อให้ชุมชนสามารถพึ่งพาตนเองในเรื่องน้ำ และมีน้ำสะอาดมีคุณภาพได้อย่างยั่งยืน และไม่ก่อให้เกิดปัญหาสิ่งแวดล้อม ซึ่งสามารถตอบโจทย์การพัฒนาที่ยั่งยืนในหัวข้อที่ 6 เรื่องน้ำสะอาดและสุขาภิบาล หัวข้อที่ 11 เรื่องความยั่งยืนของเมืองและชุมชน และหัวข้อที่ 13 การต่อสู้กับการเปลี่ยนแปลงสภาพภูมิอากาศ...” ผู้ว่าการ วว. กล่าว
ทั้งนี้ระบบผลิตน้ำประปาเป็นระบบที่แปรสภาพน้ำดิบหรือน้ำธรรมชาติให้มีความสะอาด หรือมีคุณภาพดีเพียงพอต่อการนำไปใช้ในการบริโภคและอุปโภค ซึ่งน้ำธรรมชาติถึงแม้จะมีคุณภาพดี แต่ยังไม่สามารถนำมาใช้ได้โดยตรง เพราะอาจจะมีสารปนเปื้อนปะปนอยู่ได้ โดยเฉพาะเชื้อจุลินทรีย์ต่างๆ ซึ่งอาจเป็นอันตรายต่อผู้ใช้ ดังนั้นน้ำดิบจะถูกสูบจากแหล่งน้ำผ่านระบบสูบน้ำดิบเข้าสู่กระบวนการผลิตน้ำประปาซึ่งใช้เทคโนโลยีแตกต่างกันไปตามลักษณะของน้ำดิบและคุณภาพน้ำที่ต้องการ ซึ่งกระบวนการผลิตน้ำโดยทั่วไปจะเริ่มจากการเติมสารเคมีเพื่อการสร้างและรวมตะกอน การกรอง การกำจัดจุลินทรีย์ โดยน้ำที่ผ่านการบำบัดแล้วจะถูกสูบจ่ายผ่านระบบจ่ายน้ำไปยังบ้านเรือนของประชาชนผู้ใช้น้ำ จากกระบวนการดังกล่าวส่งผลให้การผลิตน้ำประปามีผลต่อการปลดปล่อยก๊าซเรือนกระจกเป็นอย่างมาก โดยปัจจัยที่มีผลทำให้ปริมาณการปล่อยก๊าซเรือนกระจกมีความแตกต่างกัน ได้แก่ องค์ประกอบของระบบ ระดับความสูงของพื้นที่ ความต้องการใช้น้ำ ประเภทของแหล่งน้ำ และแหล่งรับน้ำ เป็นต้น โดยในแต่ละขั้นตอนการผลิตน้ำประปาจะมีการปลดปล่อยก๊าซเรือนกระจกที่เกิดขึ้นจากการใช้ไฟฟ้าและสารเคมีเป็นหลัก

นางพัทธนันท์ นาถพินิจ นักวิจัยอาวุโส ศูนย์เชี่ยวชาญนวัตกรรมหุ่นยนต์และเครื่องจักรกลอัตโนมัติ วว. ในฐานะหัวหน้าโครงการฯ กล่าวถึงผลการดำเนินงานในระยะเวลา 4 เดือน ของ วว. และพันธมิตรว่า ดำเนินงานสำเร็จตามแผนงานที่ตั้งไว้ ได้แก่ การลงนามบันทึกข้อตกลงการสร้างภาคีเครือข่ายเพื่อบูรณาการความร่วมมือ (Collaboration) การสร้างสังคมคาร์บอนต่ำ (Low Carbon Society) ระหว่าง 6 หน่วยงาน ในช่วงเดือนสิงหาคมที่ผ่านมา มีการนำเสนอแผนพัฒนาเมืองน่าอยู่ (Livable City) ภายใต้สังคมคาร์บอนต่ำ ซึ่งเป็นแผนการผลิตน้ำประปาจากน้ำฝนสำหรับชุมชนเพื่อความยั่งยืนและลดความเหลื่อมล้ำในสังคม ให้กับที่ว่าการอำเภอระโนดและจังหวัดสงขลา โดยทีมวิจัย วว. ได้ลงพื้นที่ไปร่วมประชุมหารือกับชุมชนเพื่อนำเสนอโครงการและอบรมให้ความรู้เบื้องต้นเกี่ยวกับการลดการปลดปล่อยก๊าซเรือนกระจก ซึ่งอ้างอิงสัญญาจากการประชุมรัฐภาคีกรอบอนุสัญญาสหประชาชาติว่าด้วยการเปลี่ยนแปลงสภาพภูมิอากาศ สมัยที่ 26 (COP26) อีกทั้งได้นำเสนอแนวทางการดำเนินงานเพื่อคัดเลือกพื้นที่ในการติดตั้งชุดผลิตน้ำประปาจากน้ำฝน ซึ่งได้รับความสนใจเป็นอย่างมากจากชุมชน เนื่องจากชุมชนไม่มีความรู้ในเรื่องการปลดปล่อยก๊าซเรือนกระจกและการเข้าสู่สังคมคาร์บอนต่ำ รวมทั้งมีความสนใจในการนำน้ำฝนมาใช้งาน แต่ไม่มีความรู้และความเข้าใจในความปลอดภัยที่จะนำน้ำฝนมาอุปโภคและบริโภค เนื่องจากคุณภาพน้ำประปาในชุมชนเป็นน้ำบาดาลที่ไม่มีการปรับปรุงคุณภาพน้ำก่อนการแจกจ่าย ทำให้ประชาชนไม่สามารถนำมาใช้เพื่อการบริโภคได้
นอกจากนี้ทีมวิจัย วว. ยังพบว่า ปัจจุบันชุมชนในพื้นที่ทุกครัวเรือนจำเป็นต้องซื้อน้ำบรรจุขวดเพื่อการบริโภคในปริมาณที่จำกัด แต่คุณภาพน้ำดื่มที่จำหน่ายในท้องถิ่นบางยี่ห้อยังไม่มีคุณภาพ เนื่องจากคุณภาพน้ำมีการเปลี่ยนแปลงเกิดตะกรันและตะไคร้น้ำในบรรจุภัณฑ์เมื่อเก็บไว้ระยะเวลานาน ทำให้ชุมชนขาดความปลอดภัยในการใช้น้ำและเป็นปัญหาหลักในพื้นที่ ซึ่งองค์การปกครองส่วนท้องถิ่นมีความตั้งใจในการผลักดันและสนับสนุนหากเทคโนโลยีการผลิตน้ำประปาจากน้ำฝนมีประสิทธิภาพ และได้คัดเลือกสถานที่ในการติดตั้งชุดผลิตน้ำประปาจากน้ำฝนจำนวน 7 แห่ง เพื่อให้เป็นชุมชนต้นแบบในการผลิตน้ำประปาจากน้ำฝน ได้แก่ โรงเรียน 1 แห่ง และครัวเรือน 6 แห่ง ในพื้นที่ตำบลบ้านขาว อำเภอระโนด จังหวัดสงขลา โดยช่วงแรกจะทำการติดตั้ง 2 แห่ง คือ ที่โรงเรียนชุมชมวัดบ้านขาวและบ้านผู้นำชุมชน เพื่อนำมาประเมินการปลดปล่อยก๊าซเรือนกระจกจากการผลิตน้ำประปาจากน้ำฝน เพื่อให้ได้ฐานข้อมูลในการจัดการก๊าซเรือนกระจก โดย วว. และมหาวิทยาลัยฯ เป็นผู้นำองค์ความรู้ให้กับชุมชน ให้สามารถผลิตน้ำประปาจากน้ำฝนได้ และมีการติดตั้งชุดผลิตน้ำประปาจากน้ำฝน ซึ่งจะมีการตรวจวัดคุณภาพน้ำ ในการประเมินความเป็นไปได้ของเทคโนโลยี เพื่อให้เกิดความเชื่อมั่นในเรื่องความปลอดภัยทางสาธารณะสุข และมีการประเมินความเสี่ยงทางสุขภาพ ความคุ้มค่าทางเศรษฐศาสตร์ เพื่อพิจารณาความเหมาะสมในการลงทุนขององค์การปกครองส่วนท้องถิ่นต่อไป

“...ในการดำเนินงานได้กำหนดแนวทางการร่วมลงทุนระหว่างภาครัฐและเอกชนในการขยายผลนำชุดการผลิตน้ำประปาจากน้ำฝนไปใช้ในพื้นที่อื่น และมีการรวบรวมข้อมูลการปลดปล่อยก๊าซเรือนกระจกจากการผลิตน้ำประปาด้วยน้ำฝนก่อนและหลังการติดตั้ง เปรียบเทียบกับการใช้น้ำประปาจากโรงผลิตน้ำประปาของการประปาส่วนภูมิภาคหรือการประปาหมู่บ้าน โดยศึกษาทั้งกรณีนำน้ำฝนมาใช้เป็นน้ำดื่ม และน้ำใช้ รวมทั้งการลดการใช้ขวดพลาสติกบรรจุน้ำดื่ม เพื่อประเมินการลดการปลดปล่อยก๊าซเรือนกระจก จัดทำเป็นฐานข้อมูลบัญชีการลดการปลดปล่อยก๊าซเรือนกระจกของอำเภอระโนด และเป็นแนวทางสำหรับการจัดการน้ำในชุมชน รองรับการเข้าสู่สังคมคาร์บอนต่ำของชุมชน โดยถือว่าเป็นปีฐานในการจัดการก๊าซเรือนกระจก นอกจากนั้นจะจัดเวทีชุมชน เพื่อแลกเปลี่ยนความรู้ ถ่ายทอดองค์ความรู้ให้กับชุมชนอื่นในการขยายผลไปยังพื้นที่อื่นๆ ทั่วประเทศ...” นางพัทธนันท์ นาถพินิจ นักวิจัยอาวุโส วว. กล่าว


อนึ่งจังหวัดสงขลาถือว่าเป็นพื้นที่เสี่ยงประสบภัยแล้งด้านน้ำเพื่อการอุปโภคบริโภคค่อนข้างมาก เนื่องจากฝนทิ้งช่วง ทำให้น้ำที่เก็บไว้ในอ่างเก็บน้ำ 3 แห่งของจังหวัดสงขลา มีปริมาณน้ำในอ่างเก็บน้ำต่ำกว่าเกณฑ์การเก็บกัก โดยในปี 2563 ปริมาณน้ำฝนในจังหวัดสงขลามีปริมาณน้อยกว่าค่าเฉลี่ย โดยมีเพียง 1,300 มิลลิเมตรเท่านั้น ทั้งที่ค่าเฉลี่ยอยู่ที่ 2,300 มิลลิเมตร ทำให้มีผลกระทบต่อประชาชนในพื้นที่อำเภอสทิงพระ อำเภอกระแสสินธุ์ และอำเภอระโนด และมีน้ำเค็มรุกล้ำเข้าในทะเลสาปสงขลา ทำให้ไม่สามารถสูบน้ำในทะเลสาปมาใช้ในการผลิตน้ำประปาได้ โดยอำเภอระโนดเป็นพื้นที่ที่ได้รับผลกระทบภัยแล้ง และขาดแคลนน้ำอุปโภคและบริโภคจำนวน 11 ตำบล เป็นพื้นที่ที่ประสบภัยแล้งเนื่องจากการขาดแคลนน้ำในพื้นที่เป็นระยะเวลาเวลานาน เป็นพื้นที่ห่างไกลที่ความเจริญเข้าไปไม่ทั่วถึง ชุมชนได้มีการพึ่งพาตนเองในการหาแหล่งน้ำใช้ภายในครัวเรือน ด้วยการรองน้ำฝนมาใช้เพื่อการอุปโภค เช่น นำมาใช้ในการชำระล้างร่างกาย ชำระความสะอาดในห้องน้ำ เป็นต้น แต่ยังมีชุมชนอีกหลายแห่งที่ไม่มีความเชื่อมั่นในการนำน้ำฝนมาใช้ เนื่องจากปัญหาทางมลภาวะอากาศ ที่มีฝุ่นละออง มีสารพิษตกค้าง เป็นต้น ทำให้นำน้ำฝนมาใช้ประโยชน์ได้ไม่เต็มที่ ซึ่งก่อให้เกิดปัญหาน้ำใช้ในฤดูแล้งและน้ำท่วมในฤดูฝน จากข้อมูลของกรมอนามัยพบว่า น้ำฝนที่เก็บจากภาชนะเก็บน้ำฝนในครัวเรือนทั่วประเทศตั้งแต่ปี 2552-2561 มีคุณภาพผ่านเกณฑ์เฉลี่ยร้อยละ 23.39 ที่มีการจัดเก็บที่ดี ถูกสุขลักษณะ และที่ไม่ผ่านเกณฑ์ส่วนมากพบปนเปื้อนแบคทีเรีย เนื่องจากมีการจัดเก็บที่ไม่ดี รางน้ำฝนไม่สะอาด มีมูลสัตว์ปะปน เป็นต้น

การดำเนินงานของ วว. และพันธมิตรดังกล่าว เป็นอีกก้าวสำคัญในการนำองค์ความรู้วิทยาศาสตร์ เทคโนโลยีและนวัตกรรม เข้ามาช่วยแก้ปัญหาผลกระทบจากการเปลี่ยนแปลงสภาพภูมิอากาศ ทั้งนี้จะมีการดำเนินงานอย่างต่อเนื่อง เพื่อนำไปสู่การได้ผลลัพธ์ที่ตอบโจทย์และช่วยแก้ปัญหาที่เป็นรูปธรรม ผ่านการขยายผลไปยังพื้นที่อื่นๆของประเทศต่อไป
สอบถามรายละเอียดเพิ่มเติมและรับบริการจาก ศูนย์นวัตกรรมหุ่นยนต์และเครื่องจักรกลอัตโนมัติ วว. ติดต่อได้ที่ เลขที่ 35 หมู่ 3 เทคโนธานีคลองห้า ต.คลองห้า อ.คลองหลวง จ.ปทุมธานี โทร. 0 2577 9254 (นางพัทธนันท์ นาถพินิจ)
![]()
กระทรวงการอุดมศึกษา วิทยาศาสตร์ วิจัยและนวัตกรรม (อว.)
เป็นหน่วยงานของรัฐที่จัดตั้งขึ้นเพื่อขับเคลื่อนการอุดมศึกษาไทย วิทยาศาสตร์ วิจัยและนวัตกรรม ไปสู่มาตรฐานในระดับสากล และเพิ่มอันดับความสามารถการแข่งขันในระดับนานาชาติอย่างยั่งยืน ไม่ได้มีวัตถุประสงค์เพื่อแสวงหากำไร หากท่านพบว่ามีข้อมูลใดๆ ที่ละเมิดทรัพย์สินทางปัญญาปรากฏอยู่ในเว็บไซต์นี้ โปรดแจ้งให้ทราบ เพื่อดำเนินการแก้ปัญหาดังกล่าวโดยเร็วที่สุดต่อไป
© 2020 Ministry of Higher Education, Science, Research and Innovation. ALL RIGHTS RESERVED.